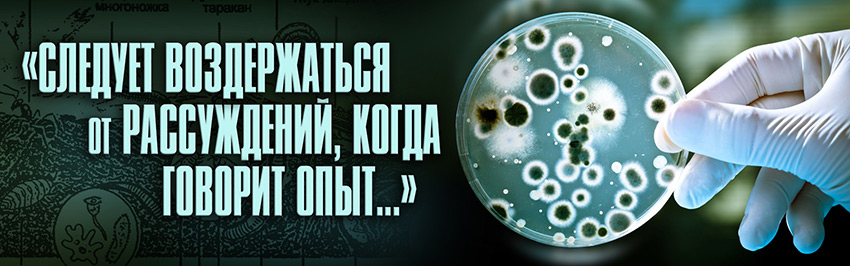

Вся философия, основана на двух вещах: любопытстве и плохом зрении
Бернаар Ле Бовье де Фонтенель (1657-1757)
Отдельные наиболее прозорливые умы и ранее высказывали смутные догадки о существовании каких-то мельчайших, не видимых простым глазом существ, повинных в распространении заразных болезней. Но догадки оставались догадками. Ведь никто и никогда их не видел.

(1632–1723)
Первым, кому выпала великая честь приоткрыть завесу в неведомый дотоле мир микроорганизмов, играющих важнейшую роль в природе и жизни людей, стал голландец по имени Антони ван Лёвенгук.
Он родился в семье мастера-корзинщика Филипса Тонисзона в Делфте (Голландия). Он взял себе фамилию Лёвенгук по названию Львиных ворот (Leeuwenpoort). Сочетание «гук» в его псевдониме означает «уголок» (hoek).
Отец умер, когда Антони было 6 лет. Мать отправила мальчика учиться в гимназию в пригород Лейдена. Дядя будущего натуралиста обучил его основам математики и физики. Но в 15 лет Антони оставил школу и уехал в Амстердам, где стал учиться торговому делу, работая в галантерейной лавке.
Там он впервые увидел простейший микроскоп — увеличивающее стекло, которое устанавливалось на небольшом штативе и использовалось текстильщиками. Вскоре он приобрёл себе такой же. Знаменитым Лёвенгука сделало это необычное увлечение.
В эти юношеские годы ему попалась удивительная книга «Микрография», настоящий бестселлер Гука, которая перевернула всю его жизнь и вдохновила Лёвенгука не на шутку. Введение к «Микрографии» объясняет, как соорудить простейший микроскоп, и торговец тканями Лёвенгук, вероятно, имел какой-то опыт в вытачивании линз, поскольку они требовались для оценки образцов льна. Но по прочтении «Микрографии» он сделался фанатичным изготовителем этих волшебных стекол и посвящал многие часы созданию микроскопов и наблюдениям с их помощью.

Антони ван Лёвенгука
В 21 год Лёвенгук вернулся в Делфт, женился и открыл свою мануфактуру. О его жизни в последующие 20 лет известно очень мало: у него было несколько детей, овдовев, он женился во второй раз, получил должность стража судебной палаты в местной ратуше. На досуге занимался цветоводством, разводил экзотических птиц, увлёкся изготовлением линз и достиг в этом виртуозного мастерства. Его линзы увеличивали в 250-300 раз. Эти замечательные линзы и оказались окном в новый мир.
В начале 1673 года на имя секретаря Лондонского Королевского общества пришло письмо от некоего доктора Граафа, в котором он сообщал «о проживающем в Голландии изобретателе по имени Антони ван Лёвенгук, изготавливающем микроскопы, далеко превосходящие известные до сих пор».
Наука должна быть благодарна доктору Граафу за это. Возможно, если бы не он – мир так бы и не узнал о Лёвенгуке, талант которого, лишённый поддержки, зачах бы. А так Королевское общество связалось с Лёвенгуком, и началась переписка.
Проводя свои исследования без всякого плана, учёный-самоучка сделал много важных открытий. Наблюдаемые им объекты он зарисовывал и описывал в письмах, которые на протяжении 50 лет отсылал в Лондонское Королевское общество. Уже в 1673 году его первое письмо было опубликовано в журнале «Философские записки».

Антони ван Лёвенгука
Он рассматривал в микроскоп всё, что попадалось на глаза: кусочек мяса, каплю дождевой воды или сенного настоя, хвостик головастика, сероватый налёт со своих зубов и т.п. Там он увидел несметное множество живых существ: они имели вид и палочек, и спиралей, и шариков. Некоторые имели причудливые отростки или реснички. Многие из них быстро двигались.

— своеобразного «учебника по микроскопии» —
изображает однолинзовый микроскоп его
современника Антони ван Лёвенгука
Вот как описывал Лёвенгук свои наблюдения: «После всех попыток узнать, какие силы в корне (хрена) действуют на язык и вызывают его раздражение, я положил кусочек корня в воду: в размягчённом состоянии его легче изучать. Он оставался в воде около 3 недель. 24 апреля 1673 года я посмотрел на эту воду под микроскопом и с большим удивлением увидел в ней огромное количество мельчайших живых существ. Некоторые из них в длину были раза в 3-4 больше, чем в ширину, хотя были не толще волосков, покрывающих тело вши... Другие имели правильную овальную форму. Был ещё и третий тип организмов, наиболее многочисленный – мельчайшие существа с хвостиками».
Когда он отослал копию своих наблюдений одноклеточных организмов в Лондон, ему не поверили. До этого об их существовании ничего не было известно. Несмотря на его репутацию исследователя, заслуживающего доверия, в Делфт отправилась группа учёных для проверки. Она подтвердила подлинность всех его исследований.
8 февраля 1680 года Лёвенгук был избран действительным членом Лондонского Королевского общества – несмотря на то, что он не знал латыни и по тогдашним правилам не мог считаться настоящим учёным. В Делфт из Лондона прислали пышный членский диплом в серебряной шкатулке с гербом общества на крышке. Позднее его приняли и во французскую академию наук.
Открытия Лёвенгука стали настоящей сенсацией. В Делфт стекались любопытствующие, микробам оказывали поистине королевские почести. Коронованные особы склоняли свои венценосные головы над волшебными линзами, желая получше рассмотреть госпожу инфузорию-туфельку. В 1698 году Лёвенгука посетил и Пётр I.
На создание «Путешествий Гулливера» Джонатана Свифта вдохновило знакомство с микроорганизмами у Лёвенгука.
Лёвенгук стал одним из первых, кто начал проводить опыты на себе. Это из его пальца шла кровь на исследование, и кусочки своей кожи он помещал под микроскоп, рассматривая её строение на различных участках тела и подсчитывая количество сосудов, её пронизывающих.

Он первый подметил, как кровь движется в мельчайших кровеносных сосудах-капиллярах, заметил, что кровь – не однородная жидкость, а живой поток великого множества мельчайших телец.
Очень важно и другое открытие Лёвенгука: в семенной жидкости он впервые увидел сперматозоиды – маленькие клетки с хвостиками. Рассматривая тоненькие пластинки мяса, Лёвенгук обнаружил, что мясо, а точнее, мышцы, состоят из микроскопических волоконец.
«В своих наблюдениях я провёл времени больше, чем некоторые думают, – писал Лёвенгук. – Однако я занимался ими с наслаждением и не заботился о болтовне тех, кто об этом так шумит: «Зачем затрачивать столько труда, какая от него польза?», но я пишу не для них, а только для любителей знаний. Все мои старания направлены к одной только цели – сделать очевидной истину и приложить полученный мной небольшой талант к тому, чтобы отвлечь людей от старых и суеверных предрассудков».
«Все мои старания направлены к одной только цели — сделать очевидной истину и приложить полученный мной небольшой талант к тому, чтобы отвлечь людей от старых и суеверных предрассудков».
Лёвенгук оставался верным корреспондентом Королевского общества до конца жизни. Заболевая, он отмечал все особенности течения своей болезни, а перед смертью скрупулёзно фиксировал угасание жизни в своём теле.
Письма Лёвенгука в Королевское общество, к учёным, к политическим и общественным деятелям того времени – Лейбницу, Роберту Гуку, Христиану Гюйгенсу и другим, были изданы ещё при его жизни и заняли 4 тома. Последний вышел в 1722 году, когда Лёвенгуку было 90 лет, чуть меньше чем за год до его смерти.
Лёвенгук так и вошёл в историю как один из крупнейших экспериментаторов своего времени. За 6 лет до смерти он написал пророческие слова, восславляя эксперимент: «Следует воздержаться от рассуждений, когда говорит опыт».
Со времени Лёвенгука и до наших дней микробиология добилась большого прогресса. Она выросла в широко разветвлённую область знаний и имеет очень большое значение и для всей человеческой практики (медицины, сельского хозяйства, промышленности), и для познания законов природы.
Тысячи исследователей по всему миру изучают многообразие микроорганизмов. И все они чтят Лёвенгука – выдающегося голландского биолога-самоучку, с которого началась история микробиологии.
Литература
Поль де Крайф. Охотники за микробами. – М., 1957.
Ред.


Основатель и издатель
Copyright © 2016–2021 Научно-популярный